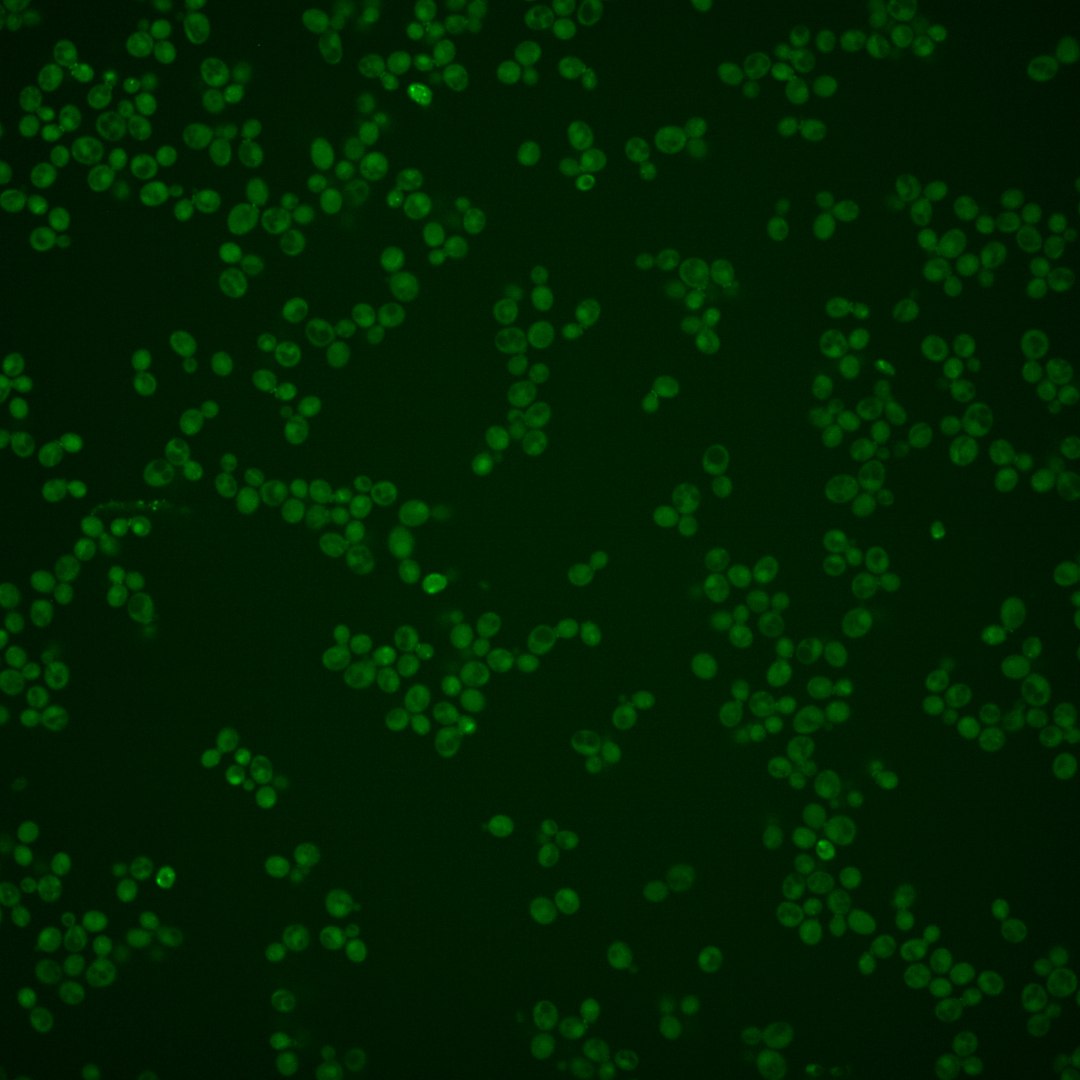
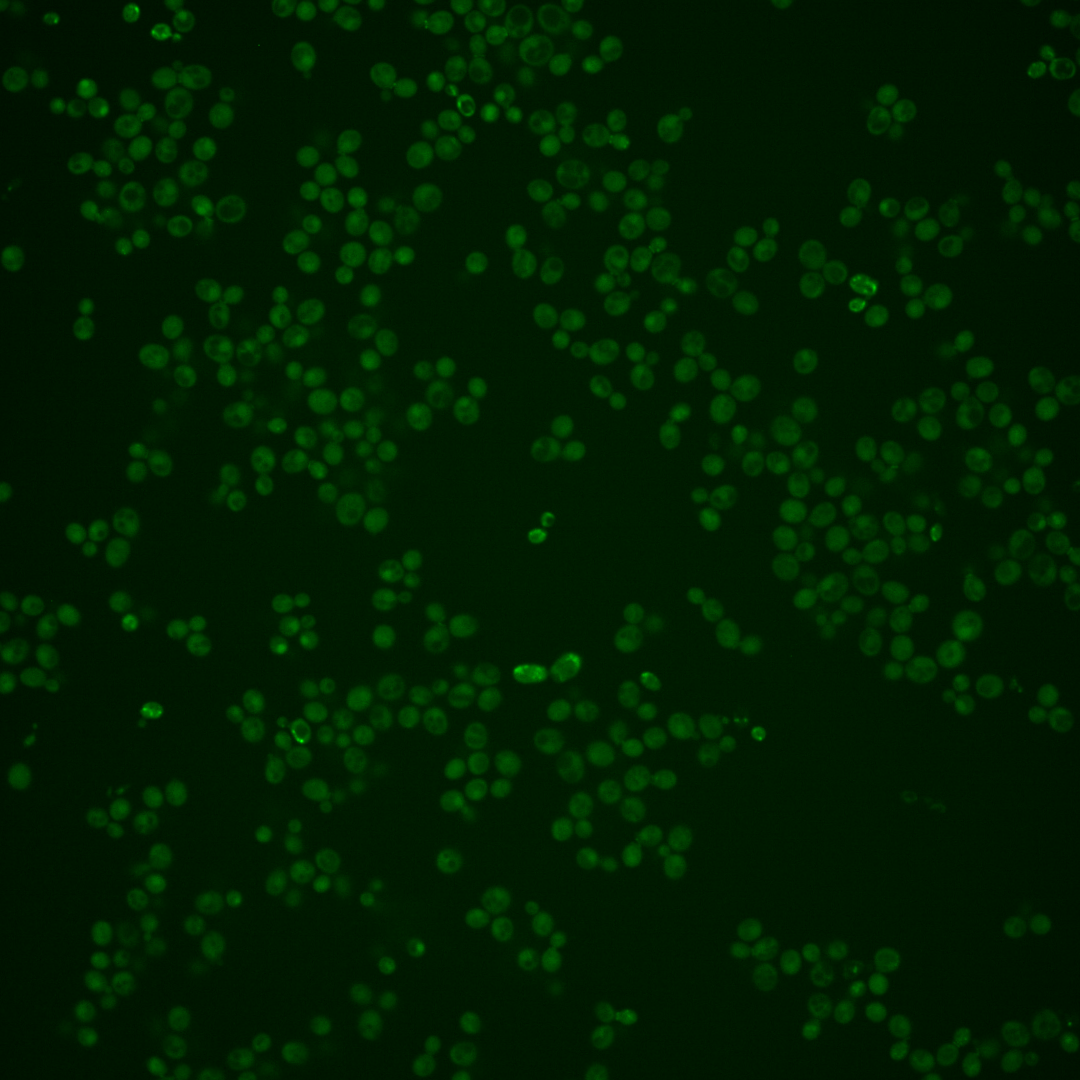
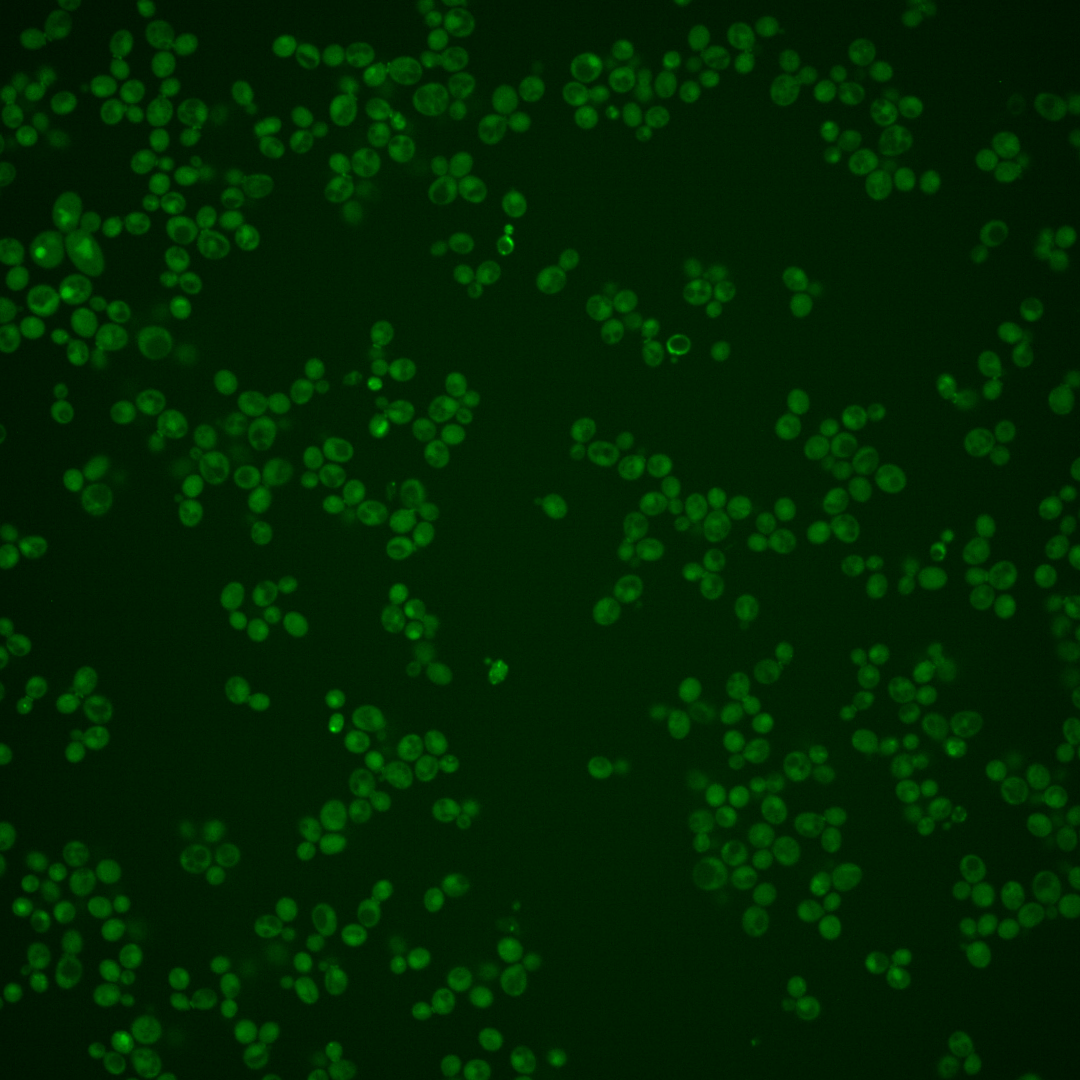
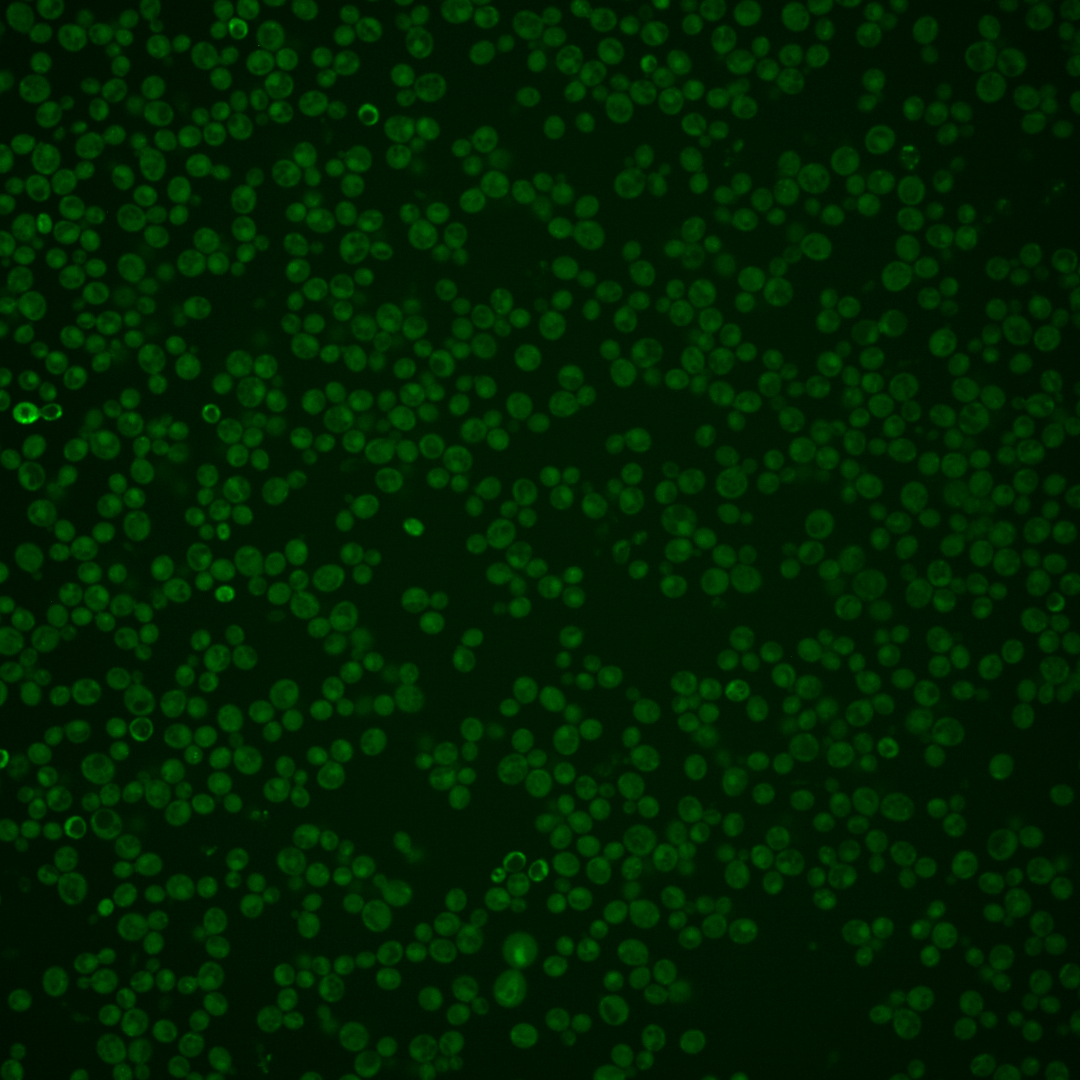

| Standard name | |
|---|---|
| Human Ortholog | |
| Description | Cell wall protein with similarity to glucanases; may play a role in conjugation during mating based on its regulation by Ste12p |
Micrographs




















































































Sub-cellular Localization
Yeast GFP Assignment
Protein Abundance
Localization Change
External localization resources
| ensLOC | DeepLoc | |||||||||||||||||||||||
|---|---|---|---|---|---|---|---|---|---|---|---|---|---|---|---|---|---|---|---|---|---|---|---|---|
| Localization | WT1 | WT2 | WT3 | RAP60 | RAP140 | RAP220 | RAP300 | RAP380 | RAP460 | RAP540 | RAP620 | RAP700 | HU80 | HU120 | HU160 | rpd3Δ_1 | rpd3Δ_2 | rpd3Δ_3 | WT1 | WT2 | WT3 | AF100 | AF140 | AF180 |
| Cortical Patches | 0 | 0 | 0 | 0 | 0 | 0 | 2 | 0 | 1 | 0 | – | 0 | 0 | 0 | 0 | 0 | 0 | 0 | 0 | 2 | 2 | 0 | 0 | 4 |
| Bud | 0 | 0 | 0 | 0 | 1 | 0 | 4 | 3 | 2 | 2 | – | 0 | 0 | 0 | 1 | 1 | 0 | 1 | 1 | 9 | 1 | 1 | 8 | 1 |
| Bud Neck | 0 | 0 | 1 | 0 | 2 | 0 | 0 | 5 | 4 | 0 | – | 0 | 0 | 0 | 1 | 1 | 0 | 0 | 0 | 2 | 1 | 1 | 4 | 2 |
| Bud Site | 0 | 0 | 0 | 0 | 0 | 0 | 0 | 0 | 0 | 0 | – | 0 | 0 | 0 | 0 | 0 | 0 | 0 | – | – | – | – | – | – |
| Cell Periphery | 0 | 1 | 0 | 0 | 0 | 0 | 0 | 0 | 2 | 0 | – | 0 | 0 | 0 | 0 | 0 | 0 | 1 | 0 | 0 | 2 | 0 | 0 | 1 |
| Cytoplasm | 47 | 149 | 81 | 22 | 90 | 122 | 144 | 110 | 74 | 79 | – | 17 | 186 | 194 | 198 | 259 | 192 | 136 | 23 | 69 | 30 | 25 | 70 | 59 |
| Endoplasmic Reticulum | 0 | 2 | 0 | 0 | 1 | 2 | 0 | 2 | 3 | 0 | – | 0 | 1 | 2 | 2 | 17 | 16 | 10 | 0 | 0 | 1 | 1 | 2 | 4 |
| Endosome | 0 | 2 | 0 | 0 | 0 | 4 | 3 | 5 | 0 | 0 | – | 0 | 0 | 1 | 0 | 19 | 13 | 4 | 8 | 6 | 2 | 3 | 4 | 6 |
| Golgi | 0 | 1 | 0 | 0 | 0 | 0 | 0 | 0 | 0 | 0 | – | 0 | 0 | 0 | 0 | 1 | 2 | 0 | 0 | 4 | 0 | 0 | 1 | 1 |
| Mitochondria | 10 | 2 | 0 | 0 | 0 | 11 | 14 | 8 | 13 | 31 | – | 9 | 0 | 2 | 1 | 5 | 1 | 2 | 5 | 6 | 7 | 3 | 6 | 5 |
| Nucleus | 2 | 3 | 2 | 2 | 3 | 9 | 18 | 19 | 14 | 7 | – | 1 | 0 | 0 | 0 | 21 | 19 | 22 | 0 | 1 | 0 | 1 | 1 | 0 |
| Nuclear Periphery | 0 | 0 | 0 | 0 | 0 | 0 | 1 | 0 | 1 | 0 | – | 1 | 0 | 2 | 0 | 0 | 0 | 0 | 0 | 0 | 0 | 0 | 0 | 1 |
| Nucleolus | 0 | 0 | 0 | 0 | 0 | 0 | 1 | 1 | 0 | 0 | – | 0 | 0 | 0 | 0 | 0 | 0 | 0 | 0 | 1 | 0 | 0 | 0 | 0 |
| Peroxisomes | 0 | 0 | 0 | 0 | 0 | 0 | 1 | 1 | 0 | 0 | – | 0 | 0 | 0 | 0 | 2 | 0 | 0 | 0 | 0 | 0 | 0 | 0 | 1 |
| SpindlePole | 0 | 0 | 0 | 0 | 0 | 2 | 0 | 1 | 0 | 0 | – | 0 | 0 | 0 | 0 | 1 | 4 | 1 | 4 | 5 | 3 | 1 | 6 | 2 |
| Vac/Vac Membrane | 5 | 30 | 3 | 4 | 24 | 29 | 44 | 28 | 17 | 18 | – | 4 | 2 | 0 | 0 | 100 | 102 | 74 | 50 | 95 | 40 | 31 | 84 | 57 |
| Unique Cell Count | 59 | 181 | 85 | 26 | 112 | 168 | 206 | 165 | 111 | 116 | 26 | 189 | 197 | 201 | 359 | 286 | 217 | 100 | 212 | 99 | 75 | 196 | 158 | |
| Labelled Cell Count | 64 | 190 | 87 | 28 | 121 | 179 | 232 | 183 | 131 | 137 | 32 | 189 | 201 | 203 | 427 | 349 | 251 | 100 | 212 | 99 | 75 | 196 | 158 | |
Yeast GFP Assignment
Protein Abundance
| Screen | WT1 | WT2 | WT3 | RAP60 | RAP140 | RAP220 | RAP300 | RAP380 | RAP460 | RAP540 | RAP620 | RAP700 | HU80 | HU120 | HU160 | rpd3Δ_1 | rpd3Δ_2 | rpd3Δ_3 | AF100 | AF140 | AF180 |
|---|---|---|---|---|---|---|---|---|---|---|---|---|---|---|---|---|---|---|---|---|---|
| Mean Cell GFP Intensity (1e-4) | 3.5 | 4.8 | 6.1 | 5.9 | 5.5 | 4.8 | 4.6 | 5.0 | 4.2 | 4.0 | – | 3.8 | 4.6 | 4.2 | 4.3 | 5.5 | 6.0 | 6.6 | 4.3 | 5.0 | 6.0 |
| Std Deviation (1e-4) | 0.4 | 1.2 | 1.9 | 4.0 | 1.8 | 1.9 | 1.3 | 1.7 | 1.0 | 1.2 | – | 0.5 | 1.5 | 1.5 | 1.8 | 1.6 | 1.6 | 2.2 | 1.3 | 2.1 | 2.5 |
| Intensity Change (Log2) | – | – | – | -0.05 | -0.17 | -0.36 | -0.41 | -0.28 | -0.56 | -0.61 | – | -0.69 | -0.42 | -0.54 | -0.5 | -0.14 | -0.03 | 0.11 | -0.51 | -0.3 | -0.02 |
Localization Change
| Localization | RAP60 | RAP140 | RAP220 | RAP300 | RAP380 | RAP460 | RAP540 | RAP620 | RAP700 | HU80 | HU120 | HU160 | rpd3Δ_1 | rpd3Δ_2 | rpd3Δ_3 |
|---|---|---|---|---|---|---|---|---|---|---|---|---|---|---|---|
| Actin | – | – | – | – | – | – | – | – | – | – | – | – | – | – | – |
| Bud | – | – | – | – | – | – | – | – | – | – | – | – | 0 | 0 | 0 |
| Bud Neck | – | – | – | – | – | – | – | – | – | – | – | – | 0 | 0 | 0 |
| Bud Site | – | – | – | – | – | – | – | – | – | – | – | – | 0 | 0 | 0 |
| Cell Periphery | – | – | – | – | – | – | – | – | – | – | – | – | 0 | 0 | 0 |
| Cyto | – | – | – | – | – | – | – | – | – | – | – | – | – | – | – |
| Endoplasmic Reticulum | – | – | – | – | – | – | – | – | – | – | – | – | 0 | 0 | 0 |
| Endosome | – | – | – | – | – | – | – | – | – | – | – | – | 0 | 0 | 0 |
| Golgi | – | – | – | – | – | – | – | – | – | – | – | – | 0 | 0 | 0 |
| Mitochondria | – | – | – | – | – | – | – | – | – | – | – | – | 0 | 0 | 0 |
| Nuclear Periphery | – | – | – | – | – | – | – | – | – | – | – | – | 0 | 0 | 0 |
| Nuc | – | – | – | – | – | – | – | – | – | – | – | – | – | – | – |
| Nucleolus | – | – | – | – | – | – | – | – | – | – | – | – | 0 | 0 | 0 |
| Peroxisomes | – | – | – | – | – | – | – | – | – | – | – | – | 0 | 0 | 0 |
| SpindlePole | – | – | – | – | – | – | – | – | – | – | – | – | 0 | 0 | 0 |
| Vac | – | – | – | – | – | – | – | – | – | – | – | – | – | – | – |
| Cortical Patches | – | – | – | – | – | – | – | – | – | – | – | – | 0 | 0 | 0 |
| Cytoplasm | – | – | – | – | – | – | – | – | – | – | – | – | 0 | 0 | 0 |
| Nucleus | – | – | – | – | – | – | – | – | – | – | – | – | 0 | 0 | 0 |
| Vacuole | – | – | – | – | – | – | – | – | – | – | – | – | 4.8 | 5.8 | 5.5 |
External localization resources
Images






























Protein Concentration and Protein Localization Data
| R1 | R2 | R3 | ||||||||||||||||
|---|---|---|---|---|---|---|---|---|---|---|---|---|---|---|---|---|---|---|
| G1 Pre-START | G1 Post-START | S/G2 | Metaphase | Anaphase | Telophase | G1 Pre-START | G1 Post-START | S/G2 | Metaphase | Anaphase | Telophase | G1 Pre-START | G1 Post-START | S/G2 | Metaphase | Anaphase | Telophase | |
| Concentration | – | – | – | – | – | – | – | – | – | – | – | – | – | – | – | – | – | – |
| Actin | – | – | – | – | – | – | – | – | – | – | – | – | – | – | – | – | – | – |
| Bud | – | – | – | – | – | – | – | – | – | – | – | – | – | – | – | – | – | – |
| Bud Neck | – | – | – | – | – | – | – | – | – | – | – | – | – | – | – | – | – | – |
| Bud Periphery | – | – | – | – | – | – | – | – | – | – | – | – | – | – | – | – | – | – |
| Bud Site | – | – | – | – | – | – | – | – | – | – | – | – | – | – | – | – | – | – |
| Cell Periphery | – | – | – | – | – | – | – | – | – | – | – | – | – | – | – | – | – | – |
| Cytoplasm | – | – | – | – | – | – | – | – | – | – | – | – | – | – | – | – | – | – |
| Cytoplasmic Foci | – | – | – | – | – | – | – | – | – | – | – | – | – | – | – | – | – | – |
| Eisosomes | – | – | – | – | – | – | – | – | – | – | – | – | – | – | – | – | – | – |
| Endoplasmic Reticulum | – | – | – | – | – | – | – | – | – | – | – | – | – | – | – | – | – | – |
| Endosome | – | – | – | – | – | – | – | – | – | – | – | – | – | – | – | – | – | – |
| Golgi | – | – | – | – | – | – | – | – | – | – | – | – | – | – | – | – | – | – |
| Lipid Particles | – | – | – | – | – | – | – | – | – | – | – | – | – | – | – | – | – | – |
| Mitochondria | – | – | – | – | – | – | – | – | – | – | – | – | – | – | – | – | – | – |
| None | – | – | – | – | – | – | – | – | – | – | – | – | – | – | – | – | – | – |
| Nuclear Periphery | – | – | – | – | – | – | – | – | – | – | – | – | – | – | – | – | – | – |
| Nucleolus | – | – | – | – | – | – | – | – | – | – | – | – | – | – | – | – | – | – |
| Nucleus | – | – | – | – | – | – | – | – | – | – | – | – | – | – | – | – | – | – |
| Peroxisomes | – | – | – | – | – | – | – | – | – | – | – | – | – | – | – | – | – | – |
| Punctate Nuclear | – | – | – | – | – | – | – | – | – | – | – | – | – | – | – | – | – | – |
| Vacuole | – | – | – | – | – | – | – | – | – | – | – | – | – | – | – | – | – | – |
| Vacuole Periphery | – | – | – | – | – | – | – | – | – | – | – | – | – | – | – | – | – | – |
Sequencing Data
| R1 | R2 | |||||||||
|---|---|---|---|---|---|---|---|---|---|---|
| G1 Post-START | S/G2 | Metaphase | Anaphase | Telophase | G1 Post-START | S/G2 | Metaphase | Anaphase | Telophase | |
| Gene Expression | 13.8857 | 7.2661 | 16.1753 | 70.3168 | 93.0908 | 6.0928 | 9.1835 | 10.7436 | 30.5208 | 129.0647 |
| Translational Efficiency | 0.3086 | 0.6969 | 0.5334 | 0.8296 | 1.2271 | 1.4095 | 0.5833 | 0.619 | 1.3682 | 1.2784 |
Hit Data
| Dataset | Hit |
|---|---|
| Protein Concentration | – |
| Protein Localization | – |
| Gene Expression | ✔ |
| Translational Efficiency | ✘ |
Micrographs
































Cell Count
| R1 | R2 | R1 & R2 | |||||||||
|---|---|---|---|---|---|---|---|---|---|---|---|
| WT | UBP2 | UBP14 | UBP2UBP14 | WT | UBP2 | UBP14 | UBP2UBP14 | WT | UBP2 | UBP14 | UBP2UBP14 |
| 1396 | 1498 | 66 | 1273 | 2076 | 2233 | 1872 | 1300 | 3472 | 3731 | 1938 | 2573 |
Protein Abundance
| R1 | R2 | R1 & R2 | ||||||||||
|---|---|---|---|---|---|---|---|---|---|---|---|---|
| WT | UBP2 | UBP14 | UBP2UBP14 | WT | UBP2 | UBP14 | UBP2UBP14 | WT | UBP2 | UBP14 | UBP2UBP14 | |
| Mean | 670.65 | 689.33 | 857.10 | 801.18 | 719.63 | 698.41 | 820.16 | 810.32 | 699.94 | 694.76 | 821.42 | 805.80 |
| Standard Deviation | 87.31 | 103.19 | 111.02 | 123.91 | 79.44 | 104.22 | 101.18 | 114.76 | 86.11 | 103.90 | 101.75 | 119.46 |
| Intensity Change Log 2 | — | 0.039635 | 0.353903 | 0.256566 | — | -0.043181 | 0.188650 | 0.171236 | — | -0.002638 | 0.270731 | 0.213029 |
Localization Score (DeepLoc)
| R1 | R2 | R1 & R2 | ||||||||||
|---|---|---|---|---|---|---|---|---|---|---|---|---|
| WT | UBP2 | UBP14 | UBP2UBP14 | WT | UBP2 | UBP14 | UBP2UBP14 | WT | UBP2 | UBP14 | UBP2UBP14 | |
| Actin | 0.000190 | 0.000458 | 0.000136 | 0.002972 | 0.000308 | 0.000308 | 0.000117 | 0.001868 | 0.000261 | 0.000368 | 0.000117 | 0.002414 |
| Bud Neck | 0.112213 | 0.044655 | 0.001670 | 0.019614 | 0.043400 | 0.055017 | 0.005228 | 0.016405 | 0.071068 | 0.050857 | 0.005106 | 0.017993 |
| Bud Site | 0.036936 | 0.026648 | 0.000747 | 0.074907 | 0.014140 | 0.027624 | 0.012287 | 0.070833 | 0.023305 | 0.027232 | 0.011894 | 0.072848 |
| Cell Periphery | 0.002455 | 0.000145 | 0.000137 | 0.000316 | 0.000369 | 0.000139 | 0.000089 | 0.000170 | 0.001208 | 0.000142 | 0.000090 | 0.000242 |
| Cytoplasm | 0.316456* | 0.378239* | 0.172269* | 0.422163* | 0.416285* | 0.361720* | 0.536879* | 0.465861* | 0.376147* | 0.368352* | 0.524462* | 0.444241* |
| Cytoplasmic Foci | 0.059979 | 0.156081 | 0.024706 | 0.014829 | 0.156267 | 0.163418 | 0.012851 | 0.021597 | 0.117552 | 0.160472 | 0.013255 | 0.018249 |
| Eisosomes | 0.000203 | 0.000099 | 0.000081 | 0.000049 | 0.000276 | 0.000094 | 0.000024 | 0.000046 | 0.000247 | 0.000096 | 0.000026 | 0.000048 |
| Endoplasmic Reticulum | 0.002025 | 0.001282 | 0.003030 | 0.002749 | 0.001547 | 0.000754 | 0.000970 | 0.001689 | 0.001739 | 0.000966 | 0.001040 | 0.002213 |
| Endosome | 0.021352 | 0.033061 | 0.003501 | 0.014527 | 0.024320 | 0.047261 | 0.003823 | 0.011838 | 0.023126 | 0.041559 | 0.003813 | 0.013168 |
| Golgi | 0.001746 | 0.003950 | 0.000057 | 0.008469 | 0.002469 | 0.004815 | 0.000070 | 0.006820 | 0.002179 | 0.004468 | 0.000070 | 0.007636 |
| Lipid Particles | 0.003965 | 0.005946 | 0.003175 | 0.000942 | 0.007436 | 0.003762 | 0.001279 | 0.001231 | 0.006041 | 0.004639 | 0.001343 | 0.001088 |
| Mitochondria | 0.004096 | 0.006056 | 0.000267 | 0.008076 | 0.003556 | 0.008587 | 0.000683 | 0.003817 | 0.003773 | 0.007570 | 0.000669 | 0.005924 |
| Mitotic Spindle | 0.001438 | 0.003861 | 0.000036 | 0.119070* | 0.002623 | 0.008296 | 0.015937 | 0.047608 | 0.002147 | 0.006516 | 0.015395 | 0.082964 |
| None | 0.006201 | 0.003776 | 0.003106 | 0.011320 | 0.002094 | 0.002076 | 0.007992 | 0.007847 | 0.003745 | 0.002759 | 0.007826 | 0.009565 |
| Nuclear Periphery | 0.000401 | 0.000544 | 0.001641 | 0.001491 | 0.000449 | 0.000345 | 0.001467 | 0.001244 | 0.000430 | 0.000425 | 0.001473 | 0.001366 |
| Nuclear Periphery Foci | 0.000314 | 0.000397 | 0.000791 | 0.001217 | 0.000242 | 0.000311 | 0.001254 | 0.000639 | 0.000271 | 0.000345 | 0.001239 | 0.000925 |
| Nucleolus | 0.001962 | 0.002505 | 0.002719 | 0.000906 | 0.001226 | 0.001638 | 0.000616 | 0.000735 | 0.001522 | 0.001986 | 0.000688 | 0.000820 |
| Nucleus | 0.106125 | 0.103529 | 0.720081* | 0.211991* | 0.122558 | 0.066238 | 0.332214* | 0.227234* | 0.115950 | 0.081210 | 0.345423* | 0.219693* |
| Peroxisomes | 0.003432 | 0.012994 | 0.000402 | 0.002999 | 0.004791 | 0.014000 | 0.000746 | 0.004382 | 0.004244 | 0.013596 | 0.000734 | 0.003698 |
| Vacuole | 0.315820* | 0.212196* | 0.061218 | 0.075438 | 0.193981 | 0.229776* | 0.065175 | 0.106241 | 0.242969* | 0.222718* | 0.065040 | 0.091001 |
| Vacuole Periphery | 0.002692 | 0.003579 | 0.000229 | 0.005956 | 0.001663 | 0.003821 | 0.000299 | 0.001896 | 0.002077 | 0.003724 | 0.000296 | 0.003904 |
Localization Changes (T-score)
| R1 | R2 | R1 & R2 | |||||||||||||
|---|---|---|---|---|---|---|---|---|---|---|---|---|---|---|---|
| UBP2_WT | UBP14_WT | UBP2UBP14_WT | UBP2UBP14_UBP2 | UBP2UBP14_UBP14 | UBP2_WT | UBP14_WT | UBP2UBP14_WT | UBP2UBP14_UBP2 | UBP2UBP14_UBP14 | UBP2_WT | UBP14_WT | UBP2UBP14_WT | UBP2UBP14_UBP2 | UBP2UBP14_UBP14 | |
| Actin | -3.15 | -0.29 | -4.16 | -2.84 | -3.79 | 0.02 | 1.63 | -1.94 | -2.03 | -2.55 | -1.52 | 1.80 | -3.89 | -3.43 | -4.62 |
| Bud Neck | 10.47 | 18.44 | 16.27 | 10.89 | -9.61 | -3.26 | 15.68 | 12.75 | 16.48 | -5.10 | 6.24 | 22.60 | 20.07 | 19.60 | -7.22 |
| Bud Site | 3.23 | 12.85 | 1.94 | -0.90 | -9.76 | -6.40 | 3.76 | -5.12 | -1.35 | -6.95 | -1.83 | 8.96 | -2.83 | -1.56 | -9.35 |
| Cell Periphery | 7.52 | 7.49 | 7.50 | -0.08 | 0.08 | 5.37 | 6.95 | 5.87 | 1.77 | -6.17 | 8.39 | 8.89 | 8.43 | 0.62 | -4.49 |
| Cytoplasm | -5.71 | 5.22 | -1.17 | 4.65 | -5.68 | 6.39 | -1.49 | 4.52 | -0.92 | 5.53 | 1.09 | -5.36 | 3.46 | 2.47 | 8.01 |
| Cytoplasmic Foci | -17.68 | 5.37 | 17.67 | 31.39 | 2.65 | -1.48 | 37.92 | 36.35 | 36.37 | -2.46 | -10.82 | 38.57 | 39.02 | 48.31 | 0.07 |
| Eisosomes | 7.09 | 5.47 | 10.36 | 7.30 | 2.32 | 10.51 | 14.25 | 12.93 | 8.94 | -7.37 | 12.64 | 18.08 | 16.31 | 11.52 | -8.71 |
| Endoplasmic Reticulum | 2.48 | -2.26 | -5.12 | -6.60 | 0.39 | 3.90 | -1.42 | -4.62 | -12.82 | -4.73 | 4.50 | -1.07 | -7.01 | -12.42 | -6.98 |
| Endosome | -5.22 | 9.98 | 11.37 | 15.61 | -0.48 | -10.09 | 17.38 | 13.57 | 19.99 | -2.65 | -11.28 | 20.61 | 17.98 | 25.28 | -2.77 |
| Golgi | -2.24 | 2.18 | -0.13 | 2.46 | -3.00 | -3.85 | 7.44 | 0.28 | 2.74 | -2.81 | -4.28 | 5.79 | 0.20 | 3.81 | -4.05 |
| Lipid Particles | -2.26 | 0.38 | 4.59 | 7.41 | 2.30 | 7.60 | 13.79 | 13.84 | 9.53 | -1.42 | 3.30 | 12.76 | 13.41 | 11.30 | -0.96 |
| Mitochondria | -1.40 | 3.34 | 0.81 | 3.49 | -5.41 | -5.50 | 5.64 | 2.51 | 7.67 | -2.68 | -4.90 | 5.58 | 2.01 | 8.13 | -5.21 |
| Mitotic Spindle | -2.12 | 2.07 | -11.02 | -10.51 | -11.49 | -3.66 | -8.36 | -8.67 | -6.84 | -2.13 | -4.22 | -8.68 | -13.95 | -12.24 | -5.25 |
| None | 1.67 | 1.99 | -1.54 | -4.60 | -4.75 | 0.07 | -7.40 | -7.49 | -7.47 | -0.30 | 1.57 | -3.76 | -5.68 | -8.74 | -1.55 |
| Nuclear Periphery | -1.96 | -4.19 | -17.09 | -16.33 | -5.26 | 1.73 | -17.62 | -19.04 | -20.58 | 0.52 | -0.02 | -18.41 | -24.59 | -24.95 | -2.43 |
| Nuclear Periphery Foci | -1.53 | -2.11 | -5.36 | -4.75 | -0.48 | -1.12 | -2.74 | -7.94 | -6.07 | 0.92 | -1.75 | -2.74 | -8.66 | -7.30 | 0.65 |
| Nucleolus | -1.12 | -0.73 | 0.86 | 1.59 | 0.94 | -2.56 | 0.30 | 3.74 | 5.13 | 1.61 | -2.09 | 1.10 | 1.41 | 2.77 | 0.36 |
| Nucleus | 0.33 | -16.22 | -27.36 | -27.33 | 9.73 | 13.92 | -34.89 | -21.90 | -29.46 | 7.95 | 10.17 | -38.38 | -34.76 | -40.97 | 8.08 |
| Peroxisomes | -7.57 | 4.52 | 3.40 | 10.74 | -1.71 | -8.84 | 10.81 | 5.20 | 11.33 | -2.19 | -11.63 | 10.13 | 6.58 | 15.68 | -2.58 |
| Vacuole | 9.68 | 10.79 | 11.65 | 2.62 | -5.22 | -4.92 | 10.71 | -1.73 | 2.32 | -10.23 | 3.23 | 19.05 | 6.48 | 3.75 | -11.88 |
| Vacuole Periphery | -1.48 | 7.69 | 2.38 | 3.42 | -2.58 | -8.50 | 12.84 | 3.69 | 9.44 | -2.18 | -6.12 | 12.79 | 3.57 | 7.91 | -3.38 |
Endocytosis
| Temp | Actin Patch (Sac6-tdTomato) | Cortical Patch (Sla1-GFP) | Late Endosome (Snf7-GFP) | Vacuole (Vph1-GFP) |
|---|---|---|---|---|
| 37℃ | ||||
| RT |
Cell Cycle Omics
CYCLoPs (Scw11-GFP)
| Gene / Allele | Actin Patch (Sac6-tdTomato) | Cortical Patch (Sla1-GFP) | Late Endosome (Snf7-GFP) | Vacuole (Sac6-tdTomato) |
|---|
| Gene | Images |
|---|
| Gene | Images |
|---|
Images are not yet available
Images are not yet available